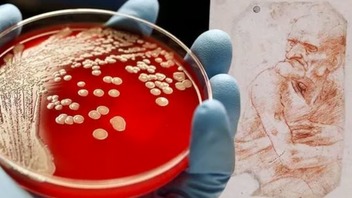
img

Новости по тегу "бактерии"
13 октября 2025
21 мая 2025
 На китайской космической станции обнаружили таинственные бактерии с "уникальными способностями"
На китайской космической станции обнаружили таинственные бактерии с "уникальными способностями"
Наука и образование
29 января 2025
19 мая 2024
13 июня 2023
6 июня 2023
 Задолго до "черной смерти": ученые обнаружили доказательства распространения бубонной чумы 4 тысячи лет назад
Задолго до "черной смерти": ученые обнаружили доказательства распространения бубонной чумы 4 тысячи лет назад
Наука и образование
1 апреля 2023
27 июня 2022
10 июля 2021
17 июня 2021
9 июня 2021
18 марта 2021
7 марта 2021
 Почти ничего не выживет: ученые рассказали, что сможет существовать на Земле через миллиард лет, фото
Почти ничего не выживет: ученые рассказали, что сможет существовать на Земле через миллиард лет, фото
Наука и образование
20 декабря 2020
8 декабря 2020
24 ноября 2020
23 ноября 2020
 В Британии создали первый в мире антибактериальный телефон, "нейтрализующий" патогены: фото
В Британии создали первый в мире антибактериальный телефон, "нейтрализующий" патогены: фото
Общество
7 октября 2020
17 апреля 2020
6 декабря 2019
Ученые разгадали главную тайну зарождения жизни на Земли
Наука и образование